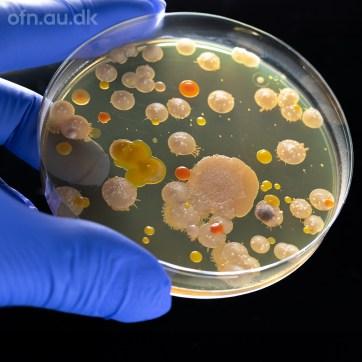

Medlemsblad for Alhedens Borgerforening 17. årgang nr. 1 Februar2025
Dette nummer af medlemsbladet leveres til alle husstande i Frederiks. Er du ikke allerede medlem af Borgerforeningen, så håber vi, at du vil blive det.

![]()
Medlemsblad for Alhedens Borgerforening 17. årgang nr. 1 Februar2025
Dette nummer af medlemsbladet leveres til alle husstande i Frederiks. Er du ikke allerede medlem af Borgerforeningen, så håber vi, at du vil blive det.


Generalforsamling
Frederiks Bio
Nyt gavlmaleri
Affaldsindsamling
Bogen om Frederiks
Juletræet blev tændt
Forårsmesse
Nu kommer der boliger på Savværket
Motorvej nord om Frederiks
Danmarks største fængsel
Cementstøberiet i Sandgraven

Hvilken begivenhed kunne samle så mange mennesker i Anlægget? Veddudetikke,så kandusesvaretinde ibladet
alhedens.borgerforening@gmail.com
Næstfmd. Marianne Rasmussen 2620 6140 mamfrederiks@gmail.com
Sekretær Fanney Dögg Sigurdardottir 4252 9720 fanneydogg82@gmail.com
Medlem Thilde Sørensen 2552 5075 nhjkarup@gmail.com
Medlem Knud Gaarn-Larsen 2545 4488 kingosvej56@gmail.com
Suppleant Jens Peter U. Jensen 2488 1244 jp@karupfragt.dk
Suppleant Arne B. Christensen 2141 9886 abchris@mail.dk
Kasserer (u.f. best.) Kai Hesselberg
Bankkonto 5959-1076720 (Husk at skrive navn, adresse og email på indbetaling) MobilePay 729017 (Husk at skrive adresse og email samt formål på indbetaling)
Foreningens mailadresse:
Redaktion
Arne Christensen, 2141 9886
Indlæg sendes til: abchris@mail.dk
Deadline: Den 10. i månederne januar, april, juli, oktober

Så har vi taget hul på 2025, og hvad er der så sket i Borgerforeningen siden sidst. En hel del, faktisk!
Den 3. november holdt vi reception i Pakhuset i anledning af udgivelsen af bogen ”Frederiks, en landsby på Alheden” skrevet af Arne Berner Christensen. I bestyrelsen betragter vi det som et stort privilegie at få lov til at udgive bogen, som giver en fantastisk indsigt i udviklingen i Frederiks – en udvikling der hele tiden har været båret af driftige lokale og ildsjæle, som har lagt utallige timer i frivilligt arbejde. En stor del af stoffet har gennem årene været bragt i Borgerforeningens medlemsblad og i P-Nyt, men i bogen er det sorteret og opdateret, så man får et godt overblik over udviklingen i Frederiks, hvilket er en gave for tilflyttere som mig, der ikke har fået historien ind med modermælken.
Det har også glædet os at kunne forære alle medlemmer af Alhedens Borgerforening et eksemplar af bogen som tak for deres støtte. Stor tak til Arne for bogen og det store, frivillige arbejde du i det hele taget gør for vores landsby.
I november kunne vi også glæde os over, at Bent Johansen algebehandlede bygninger og sten i Anlægget. Tusind tak for det, Bent!
Den 1. december blev byens juletræ tændt under festlige former. Der var fint fremmøde, og mange børn havde afleveret tegninger af julemandens kone, hvor der blandt dem blev trukket lod om, hvem der skulle at tænde juletræet. I år virkede mekanikken, så i det øjeblik, der blev trykket på den røde knap, tændte de mange lys på træet – et festligt syn. Der blev sunget julesange, julemanden hyggede med de små og delte pebernødder ud, mens køen til æbleskiver og gløgg/ saftevand hurtigt bevægede sig, så alle blev forsynet.
Tak til FDF og Dagli’Brugsen for godt samarbejde.
Som nogen måske husker, væltede juletræet sidste år i en storm få dage efter arrangementet, men takket være en ny og bedre sokkel har det stået fint i år.


Det har været spændende at følge udviklingen med det kommende gavlmaleri, hvor Tove Andreasen jævnligt holder projektgruppen orienteret. I september-oktober blev alle plader grundet og baggrundsmalet, hvorefter de kom indendørs, hvor motiverne males. Det er en stor fordel, at hun kan stå hjemme indendørs og male, for med al den regn, vi har haft i sidste par måneder, ville det have været vanskeligt (for ikke at sige umuligt) at male direkte på Brugsens væg. Der bliver heller ikke spildt tid på kørsel fra Vroue.
Økonomisk var det lidt af en skuffelse, at vi alligevel ikke fik tilskud på 30.000 kr. fra Landdistriktudvalget, men heldigvis kunne vi snart glæde os over, at Fonden for Andelskasserne i område nord havde tildelt os 25.000 kr. De blev overrakt ved en ceremoni den 2. december, hvor vi var tre fra projektgruppen, der deltog. Vi er meget taknemmelige for donationen og kan nu rent økonomisk være rolige, da vores andel i udgifterne ikke vil tømme kassen .
Tirsdag den 25. februar begynder de livestreamede foredrag i Pakhuset med forårets program, hvor det første er ”DNA’en omkring os”. Der er planlagt i alt 5 foredrag (se side 5) med spændende indhold, så vi glæder os til at se jer til de gratis foredrag.
Torsdag den 13. marts er der generalforsamling på Dagcentret, som det fremgår af opslaget på side 4. Vi håber at se rigtig mange, så vi kan få en god dialog om Alhedens Borgerforenings arbejde og om jeres ønsker og ideer til det fremtidige.
Vi må desværre sige farvel til Fanney i bestyrelsen, da hun har fået for meget at se til privat. Da hun ikke er på valg i år, indtræder 1. suppleanten i bestyrelsen, så der skal vælges en ny suppleant.
Den 27. april, søndagen før konfirmationerne i Frederiks Kirke har vi den årlige affaldsindsamling. Vi håber, at der i år vil komme flere og hjælpe, for det har ærligt talt været sløjt de sidste par år. Ja, kom nu –vi har brug for jeres hjælp. Jo flere vi er, jo

hurtigere går det, og vi skal nok sørge for kaffe og brød som belønning (i tillæg til den gode samvittighed .
Jeg vil slutte min nytårshilsen med at sige GODT NYTÅR til alle vores medlemmer og tusind tak til bestyrelsen med suppleanter, kasserer, redaktøren og alle jer frivillige hjælpere, sponsorer og annoncører som støtter arbejdet og er med til at skabe et godt lokalsamfund.

25. februar
DNA’en omkring os


11. marts
Alle dyr, planter, svampe og insekter efterlader spor af DNA der hvor de færdes – kaldet miljø-DNA. Hør om hvordan DNA’en på jorden, i luften og i vandet kan bruges til at beskrive arter, bestande og deres sammenspil i fortidens og nutidens økosystemer.
Udforskningen af Grønland – før og nu

25. marts
Den meningsfulde hjerne

Udforskningen af Grønland går langt tilbage i historien hvor ekspeditioner har givet viden om bl.a. øens natur og kultur. Grønland udforskes stadig fx for at klarlægge afsmeltningen af is, landskabet under og begges indflydelse på det globale havniveau.
Hvordan reagerer vores hjerner på fx natur, mad og musik? Hjerneskanninger og computermodellering bidrager til nye indsigter i hvordan nydelse, begær og meningsfylde er indrettet i hjernen og, med dem, hvordan vores livskvalitet kan forbedres.
Fra den 25. februar er vi klar med det nye semester, der omfatter 6 livestreamede naturvidenskabelige foredrag fra Aarhus Universitet. De vises i Pakhuset på Jernbanegade, og det er altid tirsdage kl. 19. Vi håber på sædvanlig god tilslutning, så alle vores 35 siddepladser kan komme i brug. Der er mulighed for kaffe og kage i pausen
Hvis du vil læse mere om de enkelte foredrag, så klik ind på: https://ofn.au.dk/
8. april
På tur i Mælkevejen igennem rum og tid

Kom med på en rejse –både i tid og rum – rundt i vores egen galakse, Mælkevejen. Hør bl.a. om de milliarder af stjerner, exoplaneter, gas- og støvskyer den består af. Vi skal også helt ind til det kæmpestore sorte hul der ligger i Mælkevejens centrum.
29. april Dybhavet – nyt fra en ukendt verden

Forskere har fundet uventet liv på de største havdybder og dybt i havbunden. Hør om organismer der er tilpasset det ekstreme tryk samt om bakterier i havbunden der tager tusinder af år om at dele sig og som er afgørende for livsforholdene på Jorden.
6. maj Vil resistente bakterier slå os ihjel?
Et af de største fremskridt i lægevidenskaben er opdagelsen af antibiotika, men hvordan virker de egentlig og hvorfor rammer de ikke vores egne celler? Hør om bakterier, antibiotika og om mulige løsninger på de fremvindende resistente bakterier.

I slutningen af september kunne projektgruppen endelig sætte gang i arbejdet med gavlmaleriet, da alle formaliteter var afklaret og tilskudsbeløbet på 75.000 kr. var overført til Borgerforeningen. Knud Ekholm i Alhedens Tømrer & Snedker hjemtog de mange fiberplader, som alle på værkstedet blev halveret og forsynet med skruehuller, hvorefter de blev fragtet til kunstnerens værksted i Vroue.
Her gik Tove Andreasen straks i gang med opgaven, hvor det milde vejr blev udnyttet til at grunde og baggrundsmale alle pladerne, inden de i midten af november blev flyttet indendørs, hvor kunstneren kunne begynde med det egentlige motivmaleri.


Desværre blev det ikke til noget med de forventede 30.000 kr. fra Landdistriktsudvalget, som det ellers tydede på, for man kom til den afgørelse, at fordi vi allerede havde fået ”kommunale penge” i form at det oprindelige tilskud fra Creative Viborg puljen, så kunne vi ikke tillige få tilskud fra Landdistriktsudvalget. Det var jo en bét og det 5. afslag fra fonde og puljer, hvor vi havde søgt tilskud.
Men, som en stor opmuntring, fik vi besked om, at Andelskassen Fond ville give 25.000 kr. i tilskud til projektet, og den 2. december var 3 fra projektgruppen, Gitte og Arne fra Borgerforeningen og Ryan fra Brugsforeningen, i Viborg for at modtage gaven. Tusind tak til Andelskassen. Nu er det restbeløb, som Borgerforeningens kasse må yde til projektet, nede på den størrelse, som vi fra starten havde håbet på.


Vi mødes i Pakhuset
Søndag den 27. april kl. 10
Alhedens Borgerforening inviterer alle til at tage naboen, vennerne og børnene med. Der vil være affaldssække til alle men medbring godt humør, handsker og evt. samletænger til at samle affald i buske og krat.
Alle får en afgrænset rute. Affaldet afleveres ved Pakhuset, hvor der vil være én til at tage imod. Vi giver kaffe/saft og brød til deltagerne.

Stor og lille, gammel og ung: Kom og vær med, så byen kan være ren til foråret



fantastiske jubilæumsfest.
Frederiks Open Air er fastlagt til at finde sted den

Byens flag ved Kartoffelpigen
1. januar Nytårsdag
5. februar Dronning Mary
Begivenheden, der kunne samle de mange tilskuere var Frost96’ opførelse af friluftsspil ved 250 års kartoffeltyskerjubilæum i 2009.
Flere billeder på www.alhedeborger.dk
Foto.JørgenMaagaard

Grundlovsdag
Pinsedag
Valdemarsdag + Genforening
Sct. Hans i Anlægget



5. april Forårsmesse

16. april Dronning Margrethe
20. april Påskedag



3. maj Konfirmation



4. maj Konfirmation
5. maj Danmarks Befrielse



24. maj Open Air Frederiks
26. maj Kong Frederik






8. august Open By Night
5. september Danmarks udsendte
3. oktober Kartoffelfestival



4. oktober Høstmarked/Kartoffelfestival



5. oktober Høstgudstj./Kartoffelfestival
15. oktober Kronprins Christian



1. november Rom og Whisky festival



2. november Rom og Whisky festival
25. december Juledag
= Flagallé (flagallé på andre dage kan bestilles ved Borgerforeningen)
I løbet af oktober blev den 348 sider store bog om Frederiks færdig fra trykkeriet. Vi blev undervejs nødt til at ændre ordren, så bøgerne udover limning også blev garnhæftet i ryggen, da en prøvebog viste, at limning alene ikke kunne holde. De bøger, vi nu har modtaget, er solide og holdbare.
Borgerforeningen afholdt den 3. november en reception i anledning af bogens udgivelse, hvor næsten 50 gæster var mødt op og blev beværtet med et glas vin. Der var stor ros til bogens tilblivelse og formand Gitte Nødskov takkede på Borgerforeningens vegne, fordi forfatteren havde overdraget Borgerforeningen ejerskab og udgivelsesretten til bogen. Allerede ved receptionen blev der solgt 34 eksemplarer.
Bogen er sat til salg på www.alhedeborger.dk, hvor man kan købe og betale den med MobilePay og få den bragt til postkassen eller sendt med pakkepost. Både Dagli’Brugsen og Min Kagemand har accepteret, at bogen også kan købes i disse forretninger. Det er vi meget glade for, og mange har taget bogen med i indkøbskurven.
Da Borgerforeningen har betalt for trykning af de 312 bøger, som er blevet leveret gratis til foreningens medlemmer, er det naturligvis en betydelig udgift for foreningen, så vi håber, at vi kan få udsolgt af de bøger, som vi har en lille fortjeneste på, og derved minimere det forventede underskud.


KnudGaarn-Larsenhavdeskrevetenfin anmeldelseafbogen



Efter at borgerforeningen sidste år havde stor succes med at genstarte traditionen med at tænde byens juletræ med omkring 150 deltagere, selv i dårligt vejr, så var det oplagt, at vi også i år skulle lave et arreangement.
Takket være gode kræfter, som bl.a. indebar et tæt samarbejde med FDF og velvillig sponsorering fra Dagli’Brugsen, blev arrangementet også i år vellykket.
Efter en kort velkomst var der fællessang, hvor 3 børnevenlige julesange blev sunget. De 3 vindere af børnekonkurrencen blev udtrukket.
Derefter var der æbleskiver og gløgg/saft, som FDF’erne serverede med sædvanligt håndelag, så selv om der var en lang kø, så gik det hurtigt fremad. Mange hyggede sig med den varme drik i det råkolde vejr, men hvor det heller ikke i år lykkedes at lokke snefnug ud af de grå skyer.

Vi havde indbudt julemandens assistent til at være hyggeonkel for børnene, og vi siger tusind tak til John Lauth, som igen tog opgaven på sig formummet i et julemandskostume.
Igen i år havde vi lokket med gratis æbleskiver, varm gløgg eller saft til alle samt en lille konkurrence, hvor børn skulle aflevere en tegning af julemandens kone, og der blev slået på tromme for arrangementet på forskellige måder. Vi havde derfor håbet på en deltagelse på linje med sidste år, og det kom til at stemme meget godt. Vi beregner antallet ud fra det antal æbleskiver, der blev uddelt, og det tyder på, at vi var omkring 125 personer.




De tre vindere, Thea, Mathilde og Victor, som havde lavet fine tegninger af julemandens kone.

Thea Navntoft blev udtrukket først og fik lov til at tænde lysene i det store juletræ
Borgerforeningens julebelysning var også på plads med de små lystræer i lysmasterne. Efter udskiftning til LED er det slut med at slukke hver anden lysmast, så op til denne jul, var der lys i alle 41 julebelysninger.




Sidste år lykkedes det at få genoplivet forårsmessen, og med stor succes. Det blev straks bestemt, at denne begivenhed skal fortsætte, og en arbejdsgruppe har i nogen tid været i gang med planlægningen. Den kommende forårsmesse i 2025 er fastlagt til den 5. april.
Det er naturligvis først og fremmest Handelsstandsforeningen i Frederiks og dens medlemmer, der står for messen samt Alhedehallerne, som lægger lokaler til messen. Men takket være foreningssamarbejdet, så er enkelte andre foreninger også medvirkende til at få messen op at stå. Fra Borgerforeningen vil vi i hele processen medvirke med 2 af bestyrelsens medlemmer, og også medlemsbladets redaktør er involveret i den PR-mæssige side af arrangementet.
I samarbejde med Ugeavisen Karup vil der i ugen op til blive udsendt en særlig messeavis med omtale af arrangementet og profilannoncer fra de fleste udstillere.






Flere er heldigvis blevet flinke til at give oplysning, når der skal ske noget i Frederiks, så det ikke altid er red., der må opsnuse det.
I løbet af 2024 har der været hele 170 forskellige begivenheder, som hver har haft et opslag på infostanderen ved Dagli’Brugsen, og som tillige kan ses i vores Facebook gruppe.

Til efteråret vil der igen blive afholdt Kartoffelfestival, og i år vil det igen blive med aktiviteter med kartofler på området bag Friplejehjemmet og med kåring af Årets Kartoffel.

Allerede i marts skal kartoflerne lægges til forspiring og i ugerne omkring 1. april er det tid til at sætte de kartofler, som med god pleje måske kan gøre sig gældende i konkurrencerne om ”den tungeste hjemmeavlede kartoffel” og om ”den mærkeligste kartoffel”.

Vandrepokalen kan blive din for 2 år, hvis du vinder. Det er kartofler af sorterne Sava og Ditta, der normalt leverer de største kartofler - bare så du ved det!


Tak til vores gode hjælper, Bent Johansen, som i starten af november sørgede for at algebehandle bygninger og sten i Anlægget.
Det er snart længe siden, at de lokale håndbold– og fodboldhold kunne gøre sig bemærket i de højere rækker inden for hver deres sport. Men måske er det forbigået nogens opmærksomhed, at vores lokal volleyball spillere i SKF KFUM gør en flot figur i flere klasser.
Således spiller dame senior i Danmarksserien og herre senior i 2. division vest, og i Alhedehallerne spilles jævnligt spændende kampe på højt niveau. Der oplyses om kampene på vores INFOstander og på video øverst i Facebook-gruppen - det er værd at se på.

Og glædeligt, så er der stor tilslutning og kvalitet blandt ungdomsholdene, som jævnligt gør sig gældende ved både danske og jyske mesterskaber, så fremtiden ser lys ud. Et bemærkelsesværdig flot resultat opnåede U15 pigerne, da de i foråret vandt DM i klassen. De tog guldet ved at besejre Frederiksberg i finalen, som foregik i Rødovre-hallen.
Det var ikke helt uventet, for året før havde de vundet sølv i finalen mod samme hold, og denne gang lykkedes det så at nå helt til tops. Jacob Vestergaard, der træner holdet, fortalte til ugeavisen, at ”det er rigtig stort for en lille klub som vores og i en mindre by som Frederiks. Det sker cirka hvert 50. år, så det er vildt”. I december blev holdet også pokalmester, da de vandt Final-4 stævnet i Odense.
Flere dygtige spillere fra SKF-KFUM har opnået pladser på danske landshold, og senest var Maja Vestergaard udtaget til U17 damelandsholdet i oktober.
Den 1. og 2. februar afvikles der stort Elite-træf i Alhedehallerne med hold fra nær og fjern.
Ved den sidste af efterårets livestreams fra Århus Universitet, var emnet ”Videnskaben om øl”, hvor medarbejdere fra Carlsbergs forskningslaboratorium fortalte om øllets råmaterialer og videre forarbejdning.
I løbet af foredraget var der arrangeret smagsprøver, så tilhørerne kunne smage de tydelige forskelle, som præger øltyperne.
Borgerforeningen havde købt prøvesæt, så også vores tilhørere i Pakhuset kunne smage på de 5 forskellige øltyper.

Byrådet har den 18. december har givet anlægsbevillinger på i alt 3.433.000 kr. til Boligselskabet Sct. Jørgen samt kommunegaranti på 19.409.000 kr. for den lovbestemte del af lån til opførelse af 16 almene familieboliger på området Savværket (Afd. 115) i Frederiks, som vil have en anskaffelsessum på i alt 34.327.000 kr. Det samlede antal almene boliger i Frederiks vil herefter være 87.
Den foreløbige leje, som udgør gennemsnitligt 951 kr./m2/år godkendes. Dette vil give følgende huslejer: 2-vær. (4 stk.) 85 m2 6.736 kr./md.
3-vær. (8 stk.) 94 m2 7.450 kr./md.
4-vær. (4 stk.) 104 m2 8.242 kr./md.

Skitse: 3 vær. lejlighed type B som dobbelthus
Fordeling af husene på arealet


Det tegner til at blive en vestlig motorvej Viborg Kommune har i høringssvar til Vejdirektoratets miljøkonsekvensvurdering tilkendegivet, at man afviser en løsning med udvidelse af rute 13.
Det ser derfor ud til, at valget bliver en vestlig eller østlig motorvej, som i begge udfald vil blive 2+2 sporet med 130 km/t hastighedsbegrænsning.
I øjeblikket er valget ikke truffet, men meget tyder på, at det vil blive den vestlige rute, som vil følge en tracé lige nord om Frederiks. De foreløbige planer for motorvejen:
Grønhøjvej/Karuphøjvej
Vejene bliver lukket ved motorvejen. Grønhøjvej indgår i skolebusruten til Hald Ege Skole. Det skønnes ikke, med de nuværende skoledistrikter og de nuværende kørselsberettigede skoleelever, at medføre ekstraudgifter for skolebuskørslen, hvis der etableres en parallelvej mellem Grønhøjvej og rute 12 Viborg/ Herningvej. Alternativt skal der indsættes specialkørsel, hvilket vil give en ekstraudgift på ca. 50.000 kr. pr. elev pr. år.
Nærmeste krydsningsmulighed forventes at blive ved rute 12 Viborgvej/ Herningvej. For trafikken på Grønhøjvej vest for motorvejen vil det medføre en omkørsel ad Grønhøjvej-(Grønhøj by)-
Benslehøjvej-Herningvej på ca. 8,8 km. For trafikken på Karuphøjvej øst for motorvejen vil det medføre en omvejskørsel ad Karuphøjvej-(Skelhøje by)Havredalsvej-Trehusevej-NørregadeViborgvej på ca. 8,9 km.
Grønhøjvej–Herningvej-Karuphøjvej er i dag nærmest forbindelsesvej mellem Grønhøj og Skelhøje på ca. 6,8 km. Der er en alternativ rute mellem Grønhøj og Skelhøje på strækningen HavredalsvejTrehusevej-Nørregade-Benslehøjvej på ca. 7,5 km. ´
Forslag til kommunalt vejprojekt: En parallelvej mellem Grønhøjvej og rute 12 Viborgvej/Herningvej på ca. 850 m. Anlægsudgiften skønnes at blive ca. 7,3 mio. kr. En parallelvej mellem Karuphøjvej og rute 12 Viborg/Herningvej på ca. 400 m. Anlægsudgiften skønnes at blive ca. 3,3 mio. kr. Hvis begge parallelveje anlægges, bliver forbindelsesvejen mellem Grønhøj og Skelhøje på 6,2 km. Det vil sige kortere end i dag.
Den vestlige linjeføring føres nordøst om Frederiks, hvilket skaber potentiale for etablering og udvikling af erhvervsområdet i den nordlige del af byen. Frederiks ligger dog længere væk fra motorvejen sammenlignet med de øvrige byer, hvilket betyder, at et erhvervsom-
råde her ikke vil kunne placeres i umiddelbar nærhed til motorvejen. Nærheden til motorvejstilslutningen kan imidlertid have positiv indflydelse på erhvervsudvikling i Frederiks, Midtjyllands Lufthavn, Flyvestation Karup og det kommende statsfængsel, som alle ligger i nærheden.
Udviklingen af et erhvervsområde i den nordlige del af byen vil betyde, at den fremtidige boligudvikling skal ske i byens sydlige og østlige del. Udviklingen af et erhvervsområde i byen kan have en positiv effekt på bosætningen i byen. I Frederiks forventes en moderat stigning i antallet af indbyggere i planperioden og nærhed til motorvejen kan måske være med til at understøtte denne udvikling.


Siden beslutningen om at placere fængslet ved Firehuse ved Frederiks har der været afholdt et borgermøde med naboer og lodsejere.
Mødet blev afholdt den 12. august 2024 på Frederiks Skole og gav de borgere og lodsejere, der kommer til at bo nærmest fængslet, mulighed for at stille spørgsmål og komme med kommentarer til planlægningen.
Omtrent 20 borgere deltog på mødet, hvor særligt sikkerhedszonen omkring fængslet, opkøb af boliger og byggefasen fyldte. Efterfølgende har Kriminalforsorgen indhentet tilkendegivelser fra de nærmeste naboer om deres ønsker til at blive opkøbt.
Viborg Byråd besluttede på møde den 18. december 2024, at planlægnings– og idéfase sættes i gang.
Lokalplanforlag vil indeholde bl.a.:
Fængslet omkranses af en seks meter høj betonmur. Omtrent 20 meter udenfor muren opsættes et sikkerhedshegn af trådhegn. Selve fængslet bliver i 1-3 etager og vil bestå af blandt andet cel-
ler, værksteder og personalefaciliteter. Fængslet vil have plads til ca. 400 indsatte.
Fængslet vil have omtrent 400 ansatte, der ankommer i tre eller fire skift, plus besøgende og varelevering. Det skal derfor undersøges, hvor og hvordan den bedste vejadgang til Viborgvej kan anlægges. Det vil sandsynligvis blive nødvendigt at ombygge en mindre del af Viborgvej med kanaliseringsanlæg (svingbaner), men de konkrete løsninger findes i planprocessen. Trafik forventes beskrevet i miljørapporten.
I første fase af planlægningen er der åbnet for borgernes idéer og forslag.
På viborg.dk kan du finde skema til høringssvar, som skal indsendes senest den 6. februar.
Borgermøde
Der vil blive afholdt et borgermøde i Alhedens Idræts– og Kulturcenter den 27. januar 2025 kl. 17-19. Tilmelding skal ske på viborg.nemtilmeld.dk/145/

Rikke Cramer Christiansen har i løbet af efteråret ledet en kampagne for at forbedre sikkerheden for skolebørn til Frederiks Skole, specielt skal cyklende fra og til Grønhøj gives en sikrere vej ved at etablere en cykeltunnel under den store rundkørsel på Viborgvej og dermed forbinde cykelstien fra Grønhøj med en udvidelse af cykelstien fra rundkørslen og ned til Nørregades eksisterende cykelsti, der i dag først starter ved Trehusevej. Desuden skal fodgængerfeltet på Nørregade ved skolen gøres tydeligere og mere sikker for skolebørnene.
Kampagnen kulminerede da Rikke den 18.december kunne overrække hele 1239 indsamlede underskrifter til borgmester
Ulrik Wilbek og formanden for Teknisk Udvalg Torsten Nielsen. Teknisk Udvalg indstillede på mødet den 8. januar, at fodgængerovergangen ved skolen skal renoveres på linje med tidligere forslag, hvor der kun bliver 1 fodgængerfelt med helle på midten og lysregulering. Vi har dog gjort opmærksom på, at det er mest hensigtsmæssigt at beholde det sydlige felt aht. til udkørslen fra skolen og busskuret overfor.

Vi synes, det er et flot arbejde, og Borgerforeningen støtter naturligvis op om kampagnen, som i realiteten er en opfølgning på tidligere forslag.

Cykeltunnellen var foreslået i Viborg Kommunes trafikplan fra 2017 og fulgt op med kommunale penge i 2019. Fodgængerfeltet ved skolen var egentlig en del af byfornyelsen. Desværre blev ingen af disse forslag gennemført. Rikkes ind-

Fratrafikplan2017 Nytforslag





”Du hjælper, når du handler”
Åben: Mandag-Fredag 13-17 Lørdag 10-13
Nyrupvej 3,Frederiks - Tlf. 2056 2926
Følg os på Facebook







www.hedensgolf.dk

Kartoflerne er lokalt dyrket fra Vestermarksvej 5, Frederiks ved Henrik Nordestgaard Jespersen.
Det er Sava kartofler, der er dyrket med fokus på god kvalitet, og de er kogefaste.
Der er kræset for kartoflerne i løbet af dyrkningssæsonen, og de er taget op i fint vejr.
Kartoflerne er sorteret og er ikke vasket, idet det kan forringe holdbarheden. Kartoflerne sælges i forskellige variationer. Opbevar kartoflerne mørkt og køligt.
Følg os på: facebook@hedegaardskartofler God fornøjelse og velbekomme.






Som borger i Frederiks har du sikkert bemærket nogle af de aktiviteter, som borgerforeningen har iværksat til glæde og gavn for alle. Herunder fortæller vi om nogle af dem, som vi selv ser som de vigtigste.
Vi vil gerne fortælle dig, at dit medlemskab og kontingent virkelig kommer fællesskabet til gavn. Tilsat en masse frivilligt arbejde, naturligvis!
Er du ikke allerede medlem, så håber vi, at du vil overveje at blive det. Og vi har altid brug for en frivillig indsats, stor eller lille. På vores hjemmeside www.alhedeborger.dk kan du både melde dig ind og også give besked, hvis du vil være en del af det frivillige fællesskab og tilbyde nogle timers hjælp.
Borgerforeningen ejer Anlægget på Parkallé, hvor vi har gennemført en omfattende renovering. Med megen frivillig arbejdskraft er anlæg og stier blevet nyanlagt, der er bygget 2 sheltere og en bålplads, der er bygget en flot dobbelt petanquebane og en stor legeplads med legetårn.
Og på toppen af det hele er der bygget en pavillon med overdækket terrasse og toilet. Frivillige sørger for at område og bygninger holdes vedlige.
Foreningen ejer en flot flagallé med 84 flagstænger som opbevares i et nyopført flagdepot.

Foreningen ejer Pakhuset som er fuldstændigt renoveret både inde og ude, så borgerne nu har fået et dejligt mødested midt i byen.
Foreningen har fremstillet og sørger for opsætning af 41 julebelysninger i byens hovedgade samt placerer 24 store blomsterkrukker langs hovedgaden i sommerhalvåret.
Vi vedligeholder 25 kilometersten langs Alhedestien.
Foreningen var aktivt med i arbejdet for ”Frederiks Områdefornyelse”. Vi har bl.a. skaffet finansiering til de 5 motionsstationer samt til opsætning af Info-stander, hvor vi året igennem oplyser om 150-200 forskellige aktiviteter i byen.
Foreningen står bag skabelsen af et nyt stort 23x2 meter gavlmaleri på Dagli’Brugsens væg mod Kongemosevej.
Foreningen har en hjemmeside (www.alhedeborger.dk) samt en Facebookgruppe (alhedens borgerforening, frederiks) for Frederiksborgere med flere end 2800 medlemmer. Vi fremstiller en turistfolder for Frederiks, som leveres til ejendomsmæglere og kan fås hos byens handlende.
Foreningen har udgivet ”Frederiks, en landsby på Alheden” (afArneBernerChristensen) og hvert medlem har fået en bog.
Borgerforeningen er byens kontakt og talsmand over for Viborg Byråd og forvaltning.





Denne udgave af medlemsbladet leveres til alle husstande i Frederiks og dermed også til personer, der ikke er medlem
Er du i tvivl, om du er medlem? Sammen med dette medlemsblad, vil du enten få en mail eller et indbetalingskort. Hvis du ikke modtager nævnte, så er du ikke medlem - endnu!

Derved støtter du fællesskabet og får medindflydelse på lokalsamfundets udvikling.
Kontingent for medlemskab er kun:
Husstand 250 kr. årligt
Personligt 125 kr. årligt
Betal ..med Netbank til konto 5959-1076720
Husk at skrive navn, adresse og e-mail på indbetalingen ..med MobilePay til 72 90 17
Husk at tilføje kommentar: adresse, e-mail og ”kontingent”
Du kan også melde dig ind på vores hjemmeside www.alhedeborger.dk
Kasserer Kai Hesselberg, kasserer.alhedeborger@gmail.com, tlf. 3023 3278 Formand Gitte Nødskov, alhedens.borgerforening@gmail.com, tlf. 3059 0130
Også denne artikel - samt 49 andre historier fra Frederiks - kan du finde i bogen ”Frederiks - en landsby på Alheden”. Et lille restparti af bogen kan endnu købes (www.alhedeborger.dk)
Frederiks Cementstøberi blev startet af murer Frederik Mogensen (1885-1974) formentlig i 1906, og det giver god mening, for på det tidspunkt kom jernbanen til Frederiks. Det gav et voldsomt skub i byens udvikling, og der kom gang i en masse byggeri, så byens og egnens håndværkere og leverandører, blandt andet Frederiks Savværk, havde masser af arbejde i de følgende år.
Flere firmaer på banen
Denstorebyggeaktivitetfiksikkert foretagsommefolkibyentilatse,at dervarmulighederforforretninger. UdoveratFrederiksCementstøberier oprettet,sesi1907avisannoncerfra A/SFrederiksCementvarefabrik”ved FrederiksSt.”ogfrasnedkerogkøbmandChr.Jacobsen,somharetableret etFælles-UdsalgafBygningsartikler fraStendalsgaardogHavrdalSavværker,ligeledes”vedFrederiksSt.”Uden tvivlharogsaandrelokalehandværkerehaftforbindelser,sadeharkunnet skaffedebygningsartikler,dervar brugfor.

Denupræciseadresse”vedFrederiks
St.”skyldessikkertdels,atderendnu ikkevarfastetableredegadenavneog husnumreogdels,fordivarerneblev leveretabFrederiksStation.
Detharvoldtred.nogethovedbrud, hvordandetforholdtsigmedFrederiksCementstøberiogA/SMidtjyllandsCementvarefabrik.
Detmestetydedepa,atdervartaleom toforskelligeforretninger,idetdeangivnetelefonnumreforsidstnævnteA/ Svartilhhv.SogneradsformandJohan C.CrameroghotelejerJensStordal,




hvorimodFrederikMogensenogFrederiksCementstøberiikkevarnævnt. Detstorevaretilbudtydededaogsapa, atdetoherrerkunneværemellemhandlereelleragenterforetstørre udenbysfirma,somaltsaikkehavde nogetmedFrederiksCementstøberiat gøre.

Imidlertiderder,somFrederikMogensensd.y.læserregnskaberne,næsten kuntaleomsalgafcementvarerog ikkedeøvrigebygningsartikler,som derreklameresfor,bortsetfrastøbejernsgenstandesomstaldvinduerog kakkelovne.
Detblevikkemereforklarligt,dadeti regnskabsbøgerfracementstøberiet, somblevførtafFrederikMogensen,og somFrederikMogensensbarnebarn, sønafHenryMogensen,haropbevaret, fremgar,atregnskaberneerforA/S FrederiksCementvarefabrik!
Enantagetløsningvistesig,daKnud ErikJohansenkunneviseetskødefra dengangi1954,dahansfarovertog cementstøberiet.Herfremgardet,at sælgerneafFrederiksCementstøberi erhelefirepersoner:FrederikMogensen,JensStordal,JohanChr.Cramerog AndersPederBrauner.
Detteforholdmaformodesatbetyde, atdissefireudgjordebestyrelsenaf A/SFrederiksCementvarefabrik,som saerselskabet,derejerFrederiksCementstøberi,hvorFrederikMogensen erdriftsleder,ogderforstarsomsælgere.Deterdenenesteplausibleforklaringpa,atdeallefireerunderskrivere.
Sa,deterrigtigtnok,atderertoforskelligefirmaer,blotmeddenparentes,atdeteneA/Serejerafdetandet firma,ogdermedirealitetenetog samme.Mendereraltsaikkemeget, dertyderpa,atselskaberneharhaft nogenvidereomsætningafandetend cementvarer.
OmFrederikMogensenellerenafde andreharværetformandforAktieselskabet,kanikkeudledes,menderer ingentvivlom,atdeterFrederikMogensen,derharværethovedindehaver ogdendrivendekraftiselskabetogi cementstøberiet.
JensStordalkandoghuske,athans bedstefarogsatogdeliarbejdeticementstøberiet,fordetharhanselv
overværet,dahansomdrengvarmed isandgraven.
FrederikMogensenharjohaftsithovederhvervsommurermester.Afde sammeregnskabsbøgerkanFrederik Mogensend.y.uddrage,athansbedstefadersmurerfirmaover50ar,fra 1910til1960,stodforopførelsenaf flerehundredestatsejendommepa egnen,forudenandetalmindeligtbyggeri!Dethartydeligvisværetentemmeligomfattendeforretningmedflere ansatte,foralledemurstenkanhan ikkehavelagtenemand.
Cementstøberiet hed altid Sandgraven
CementstøberietogsandgraveniFrederikslapadetomrade,deridager Nørregade17ogetstortomradebagved.Dethedoghedderifolkemunde aldrigandetendSandgraven.Huset, deridagliggerpagrunden,blevopført i1906,ogdeterdetsammesomcementstøberietshus,mendetblevsenereombyggettilboligadflereomgange.MurermesterFrederikMogensenboedeselvoverforpaNørregade 16iethus,somhanopførtei1909,og naturligvisharhanselvharleveret stenenetilhuset.
På billedet fra ca. 1910 ses vindmøllen til cementstøberiet til venstre over taget på maler Sørensens hus. (Søndergade 11).
Husene Søndergade 3-9 er endnu ikke bygget.
Foto: Karup Egnsarkiv


Før 1960. Nørregade 17, øverst tv. ses Vestergade 4. Kirstine havde butik bag vinduet th. og indgangsdøren er lige tv. for vinduet. Den øverste del af sandgraven er nu fyldt op med affald og overdækket med jord. Hus og skur længere nede er en del af støberiet, som stadig står i sandgraven. Også den del bliver efterhånden fyldt op.

Før 1960. Vestergade 4 og bagved ses den nederste del af sandgraven, hvor tag og gavl af huset nu er revet ned. Indtil da havde Johansens holdt høns i skuret og havde sågar en gris gående, som næsten blev tam, så børnene ville ikke spise noget af grisen, da den blev slagtet. Både husruinen og skuret blev en del af opfyldet, da efterhånden hele grunden blev fyldt op og dækket med jord.
Med egen vindmølle
KnudErikJohansenkunneogsahuske frasinbarndom,atderetstykkefra husetpasydsidenstadiglakraftige betonfundamenterfraenvindmølle, somengangstodder.Ogrigtignok-pa etbilledefra1910sermantydeligt vindmøllenoverhustageneienposition,derpassermedsandgraven.
Dacementstøberietblevstarteti1906, varderendnuikkeoffentligvandforsyningiFrederiks,sastøberietharnaturligvisværetnødttilselvatpumpe vandop,derskullebrugestilstøbningen.Ommøllenogsakanværebrugttil atskaffeelektricitetvidesikke.
SomidagvarderogsadengangindkørselfraNørregade,forbihusetog viderenedtilsandgravenogstøberiet. Desudenvarderenlængereindkørsel frahjørnetafVestergadelangsNørregadeogovergrunden,hvorTrinity liggeridag.
Detsesendnuidag,atheleomradet liggernogetlavereiterrænet,endde omgivendearealer,ogdetgælderogsa padenandensideafNørregade.Deter ennaturliglavningfraistiden,ogder løbenlillebæk,somblevlagtirørundervejen,dadenneblevnivelleret,og vejenblevvandretiforholdtilomgivelserne,menomradernepabegge siderafvejenliggerstadigbetydeligt lavere.Denoprindeligesandgraver selvfølgeligblevetyderligereudhulet, efterhandensomderblevbrugtsand tilstøbningen.
En betydelig produktion
Pastøberietblevderfremstilletforskelligecementvarersommursten, tagstenogrør.Altbetonblevblandet pastedet,sikkertmedcementfraAalborg,ogmanhavdemangesindrige
støbemaskinerogformetildeforskelligeprodukter.
Ideefterladteregnskabsbøgerfrade førstear,fremgardet,atdetfaktiskvar envirksomhedmedenbetydeligproduktion.Derhararligtværetfremstilletoptil130.000murstenog40.000 tagstenmedenomsætningpaoptil 18.000kr.
Detharværetvanskeligtpræcistat vide,hvorstortetomrade,somsandgravenogcementstøberietomfattede. Degulestregerpakortetlængere fremmeiartiklener,hvadderharkunnetudledesgennemsamtaler.
Alle,vihartaltmed,fortællersamstemmende,atsandgravenvarenpopulærlegepladsforbørneneiFrederiks.
OrlaKristensen,somboedeiWestend paVestergade21,ogmangeafhans legekammerater,legedeoftepaskræntennedtilsandgravenefterfyraften, fornardervarfolkisandgravenvar detforbudtomrade.Demoredesig medatkørenedadbakkenpaforskelligekøretøjerfraWestend,hvordet varsærligstejlt,ogomvinterenvar derenskønkælkebakkeheltoppefra Nørregadeognedigraven,oghvis manikkehavdeenkælk,gikturenofte somen”røvtur”paenplasticpose.
FrederikMogensend.y.boedesom barni1950’ernepaHedevej6,oghan fortæller,atdeflestebørniomradet brugtesandgravensomlegeplads.I skolenvarhansbedstekammerat KnudErikJohansen,somboedeisandgraven,ogefterskolenkombegge drengeilærehosFrederiksfar,Henry Mogensen,somhavdeetmurerfirma sammenmedHartvigVesth.
Mange arbejdere gennem tiden
Derhargennemareneværetmange arbejdereansatvedcementstøberiet. CharlotteVillerkanfortælle,athendes oldefar,SørenCarlsenLaursengift medPetrine,varcementstøberiFrederiksiarene1925-1940.Sørenssøn, AndersLaursen,somboedepaVestergade10arbejdedeogsapastøberiet. EjnerBraunerDanielsenarbejdedepa cementstøberietsidsti1940’erne.
JensDamgaardhusker,ati194050’ernevarderencementstøber,der havdefaettilnavnet”RødeAnton”,og somvistnokboedepaRønnealle.Han fikdetnavn,fordihanstøbtecementtagsten,derblevindfarvetmedrødt, ogbadehamoghanstøjvarligesarød somdetagsten,hanstøbte.Detrøde farvepulver,somderblevstøbtmedpa denforrestedelafpladsenopimod Nørregade,vargenereltetproblem, idetogsaomgivelserneogsagarhuset
badeud–ogindvendigtbarsporaffarven.
OrlaKristensensonkel,LaustChristensenvarcementstøberogstøbtemange mursten.HanvargiftmedAlma,ogde boedeTværgade4.DevarbeggedøvstummeogOrlakommegetpabesøg hosdemsombarnogung,ogdahan ligeledeshavdeenmoster(søstertil Laust)derogsavardøv,lærtehanhurtigtderesdøve/fingersprog.
FrederikMogensenfortæller,atnæstenaltisandgravenvarmanueltarbejdemedfolk,derstodoghandblandedecementogsand.Dervarnogle storebetonpladerlagtudibundenaf sandgraven,ogdeblevbrugtsomblandepladser.
Derkunnesastaenmandogskovle sandopimaskeenkubikmeterog

Sandgraven og cementstøberiet 1954. Det vides ikke præcist, hvor området var afgrænset, men det viste er den bedste formodning ud fra, hvad der fortælles
blandedetmedtørcement,derefteret antalspandevandovenibunken,og efteratvandetvartrængtindisandet, blevhelebunkenblandetmedenskovl tildethavdedenrigtigekonsistens. Derefterkombetonenopienmaskine, hvordetblevvibreretvedatdrejepa ethandsvingogkomderfranediformenetiltagsten,murstenogandet.
Johansens i 48 år
HaraldJohansen,derkomfraenlandejendomiSejbæk,købteejendommen inovember1954ogflyttedetilFrederiksi1956,oghanblevderfornuindehaverafFrederiksCementstøberi.
DethuskerInge-LiseSterup,fordet varsammear,hunstartedei1.klassei FrederiksSkole.HaraldKriegbaum JohansenogKirstineGudelundJohansenvarforældretilbørneneInge-Lise, KnudErikogKarlAage.
KaiSørensensforældrehavdetidligere boetiFrederiks,hvorKaisbedstemor
Jensignehavdeskolebørneneselskede slikbutikiVillaPaxpaNørregade32. Omkring1958flyttedeKaiogforældreneigentilbyen,hvorKaismoster ogonkel,KirstineogHaraldJohansen, padettidspunktboedeihusetpaNørregade17.
Cementstøberiet lukkes ned EfterovertagelsenfortsatteHaraldJohansennogentidmedatlavecementmursten,menshuset,somindtilda havdeværetendelafvirksomheden, blevfuldstændigrenoveret,ogdethele blevindrettettilbeboelse.SomOrla Kristensenhuskerdet,varderikke længerecementstøberi,mendetflød medalskensaffald,somblevbrugtil opfyldning.Hanmener,atomradet blevlukketogdækketmedjordsidsti 1950’erne.
Detpassermegetgodt,fordetvarHaraldJohansen,derlukkedecementstøberietogfikgrusgravenfyldtopmed det,mandengangkaldteopfyld,men

Sandgraven i dag
sommanidagvillekaldeaffald.Det sketeoverenarrække,ogopfyldvar foreksempelmedbygningsaffaldfra dengamlepræstegardsladeogoverskudsjordfrabyggerietafdennyeskolesamtfrakloakeringognedgravning affjernvarmeibyen.
KnudErikJohansenhusker,atdetværstevaregentlig,atKristianPoulsen, somhavdefirestorebelgierhesteog kørtetræfraskoven,deponeredehestegødningidennederstedelafgraven.Dervarikkenogetivejenmed gødningen,detvarmerenaturligtend detmesteafdetandet,mendetvar desværreslemttilattiltrækkerotter.
Ovenpadetheleblevderlagtjordog plantetogiendelafomradetblevder anlagtenstorhave.
Kirstines butik
KirstineJohansenhavdealleredeinovember1956faetnæringsbrevsom handlendeiFrederiksogsasnarthuset varsatistand,startedehunenlille forretningihuset,hvorhunhandlede medgrøntsagerfradengamlehaveog efterhandenogsafradenstorenyehave.Senereblevbutikkenudvidet,og hunbegyndteogsaathandlemedRønbjergis,sodavandogslik.Brugseni Grønhøjvarenafdefastekunder,som næstenhverdaghentedefriskegrøntsagerhosKirstine.
Grunden opdeles i flere matrikler
Omradetmeddengamlesandgravog cementstøberiblevsenereopdelti4 matrikler,ogdereropførthuseneHedevej1C,DogEsamtVestergade2 (Trinity).
Sv.ErikChristensenkøbteBorrits gamlegaragepaHedevej(somiøvrigt liggerderendnu),ogsammenmed KnudErikJohansenudstykkedede omradet.SvendErikhavde2parceller paHedevej,somhansolgtevidere,og deeridagbebyggetmedHedevej1A ogBsamt1F.
Idennederstedelafdentidligere sandgravhavdeKnudErikoghanssøskende2parceller.Padeneneopførte KnudEriki1980ethusmedadresse Hedevej1C,denandenblevsolgtvidere,ogderblevi1990opførtethus med2lejligheder,Hedevej1Dog1E. KnudErikfortæller,athusetpa1Cer fundamenteret4meternedpa16opmuredepiller,netopfordiundergrundeneropfyld.
KirstineogHaraldJohansenboedei husetpaNørregade17,indtildepr.1. september2002solgteejendommen ogflyttedetilældreboligpaParkvænget.Dedødemed½arsmellemrumi


Før 1970. Nørregade 17, hvor der er foretaget en tilbygning, og Kirstines butik er blevet udvidet med ny indgang og stort butiksvindue mod vejen.

Nørregade 17 i dag
















Kig indenfor, eller ring og bestil tid Skovvej 1A, Frederiks Tlf. 8666 1424
REPARATION & OMFORANDRING
STORT UDVALG AFDÅBSKJOLER

Ruth Vinkler
Søndergade 8A, Frederiks
Tlf. 4111 4947




BELÆGNINGSARBEJDE
MASKINUDLEJNING
HAVEANLÆG
INDKØRSLER

JORDARBEJDE KLOAKARBEJDE
STØBEARBEJDE



Hundelufteren lagde mærke til...

..at ejendommen Søndergade 6 nu forsvinder, da ejer har besluttet at nedrive bebyggelsen… det var en af Frederiks’ ældste bygninger fra 1908 og den har huset flere forretninger bl.a. træskofabrikation, sadelmagerværksted, Andelskassen, Shell benzintank, cykelforretning og senest skoforretning...ombygget til lejligheder i 1986.






..at i slutningen af november blev man endelig færdig med opretningen af fortov og cykelsti på en stor del af Søndergade ...og i starten af december blev stregerne malet op ...alt sammen dejligt og tiltrængt


..at i forbindelse med asfaltarbejdet, blev kloaken på hjørnet ved Kongemosevej endelig repareret ...det var tiltrængt, for den var altid stoppet og var da også for dårligt lavet, fortalte de
Hundelufteren lagde mærke til...
..at først i november var der opsat måleudstyr på Solvænget … spoler i slangerne kan måle både antal biler, hvornår de passerer og hvor hurtigt, de kører


..at det var tvivlsomt, om de to høje graner, som for nogle måneder siden blev plantet i Trehuseparken, kunne få fat og gro videre ...det gav blæsten snart svar på
(Meldttilborgertip)



..at i slutningen af november begyndte der igen at være aktivitet på Trælastgrunden, så der gøres klar til byggemodning i det nye år

..at den brændte del af Sol O Mio er ved at blive genopbygget


at det er en skam, at de pæne sten forsvandt, og vi i stedet fik en klump asfalt som rundkørsel ..rundkørslen var egentlig med i projekt byforskønnelse, men dette er nærmere af-forskønnelse ...kommunen er blevet bedt om at bringe chausséstenene tilbage på plads… efter 4 mdr. og en påmindelse er der nu svaret, at entreprenøren ikke har glemt stenbelægningen, men reetablering er ikke blevet prioriteret, dadensandsynligvisskalombyggesindenfornærmestefremtid ..det lyder lovende, så denne gang håber vi, at det gennemføres


..at Alhedemarked åbnede 16-17. november i det tidligere menighedshus på Holbergsgade ...der bliver også arrangeret fællesspisning, og desuden flytter Christians cykelværksted til adressen








